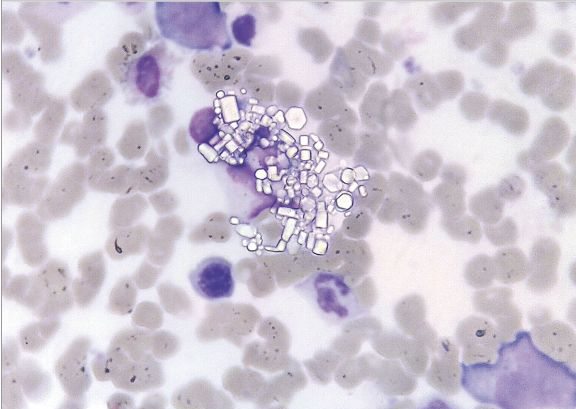

基因疗法临床试验,意外改变受试者发色

基因疗法研究示意图。(Shutterstock)
研究人员在对一种利用基因疗法治疗胱氨酸贮积症的临床试验过程中发现了出乎意料的副作用:五名参与者中有四名患者头发的颜色出现了变化。
胱氨酸贮积症(cystinosis)是一种染色体遗传性疾病,导致身体累积太多胱氨酸。这种氨基酸会结晶,在身体各处产生胱氨酸晶体。患者常见呕吐、脱水等症状,有的还有更严重的问题。此病的患者平均寿命只有28.5岁。
20岁的乔丹·詹兹(Jordan Janz)告诉《大西洋》(The Atlantic)杂志,他是这项基因疗法的参与者之一。医生从他的骨髓中抽取了血液干细胞,在实验室内进行基因编辑。与此同时,詹兹还要接受化疗,摧毁其余变异的细胞。
詹兹说治疗过程给“身体造成了巨大的痛苦”。化疗导致他嘴里长了很多脓疮,相当痛苦。当然,和大部分化疗患者一样,他一头淡金色的头发全掉光了。
医生对他的干细胞进行基因编辑后放回体内,他的白细胞开始分泌正确的蛋白,逐渐清除体内累积的胱氨酸晶体。
化疗结束一段时间后,他的头发开始重新长出来。奇怪的是,他的新头发颜色比以前深了很多,接近黑色。现在,距离这项疗法试验几年之后,他的头发稳定为深金色——与接受治疗之前的发色完全不一样。

为什么会出现这个变化?研究人员称,这是因为胱氨酸病的基因对身体毛发的色素有一定的影响,基因治疗去掉了这部分基因影响后,原来的发色得到体现。
《大西洋》(The Atlantic)杂志的报道称,这种疗法并不能逆转此病已经对身体造成的伤害,但是可以阻止这种疾病的发展。
组织这项临床试验的主要研究者之一加州大学圣地亚哥分校(UC San Diego)的干细胞科学家斯蒂芬妮·切尔基(Stephanie Cherqui)说,这项疗法可以帮助患病儿童不用一生被此病折磨。

发表你的评论吧返回顶部
!评论内容需包含中文
